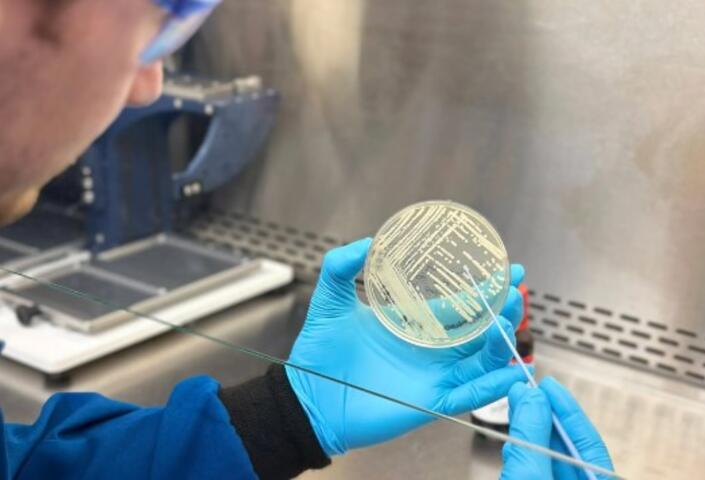

Stories from
Alumni
Harvard Griffin GSAS Newsletter and Podcast
Get the Latest Updates
Subscribe to Colloquy Podcast
Conversations with scholars and thinkers from Harvard's PhD community
Apple Podcasts
SpotifySimplecast